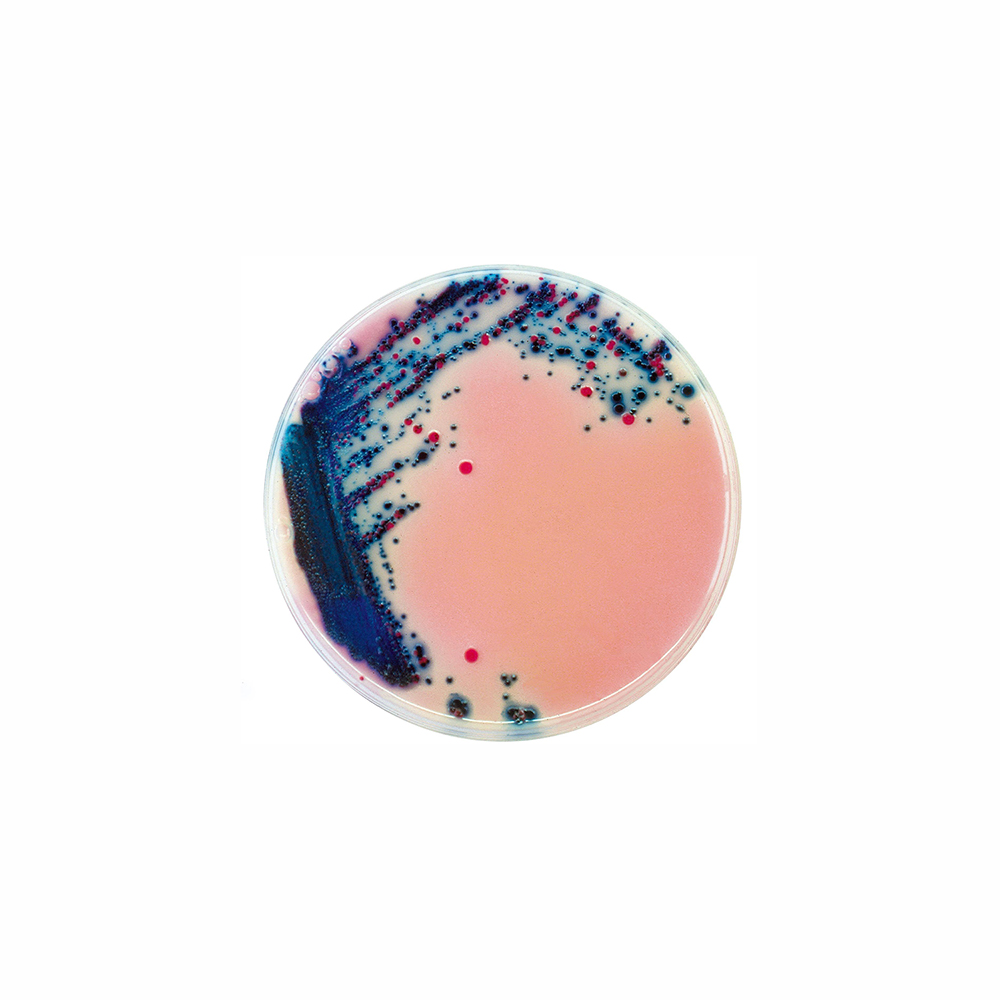

Über das Produkt
Chromogenes Medium für den Nachweis und die Isolierung von Salmonella-Arten in Lebensmittelproben.
Rambach-Agar Fertigplatten
Chromogenes Medium für den Nachweis und die Isolierung von Salmonella-Arten in Lebensmittelproben.